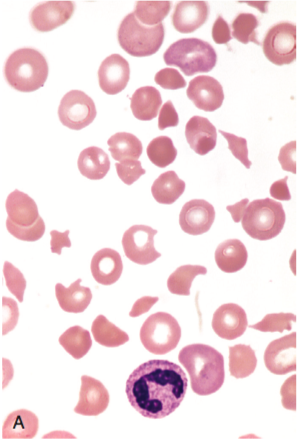

Schistocytes are defined as circulating red blood cell fragments. Detection of schistocytes is an important clue for the diagnosis of thrombotic microangiopathy (TMA), which includes both thrombotic thrombocytopenic purpura (TTP) and hemolytic-uremic syndrome (HUS). Other causes of schistocyte formation include structural abnormalities of heart and great vessels, malfunctioning prosthetic valve, HELLP syndrome, malignant hypertension, and metastatic carcinoma. A more recent indication for schistocyte counting is monitoring bone marrow transplant patients for the onset of TMA, which is a frequent and severe complication. Non-TMA causes of red blood cell fragmentation include red blood cell membrane defects, thalassemia, megaloblastic anemia, primary myelofibrosis, and thermal injury. The red blood cell fragments in these cases show high variability in shapes and marked aniso-poikilocytosis which are not specific for the diagnosis of TMA.
In 2012, the International Council for Standardization in Hematology (ICSH) published recommendations for the identification, quantitation, and diagnostic value of schistocytes. ICSH updated their recommendations in 2021.
The updated recommendations included:
- Schistocytes shall be counted on PB smears using an OM at medium (x400) or high (x1000) magnification and expressed as a percentage of RBCs after counting at least 1,000 RBCs (confirmed).
- A schistocyte count should be requested and carried out when a diagnosis of TMA (also named MAHAT or MAHA) caused by red cell mechanical damage is suspected, usually, although not exclusively, in the presence of thrombocytopenia.
- Schistocytes shall be identified based on specific positive morphological criteria: they are always smaller than intact red cells and homogeneously stained in most cases. They can have the shape of fragments with sharp angles and straight borders, small crescents, helmet cells, keratocytes, or microspherocytes (only in the presence of the aforementioned RBC shapes)
- A schistocyte count should be considered clinically meaningful if schistocytes represent a prominent or predominant morphological RBC abnormality in the smear, and other RBC abnormalities are only slight or moderate (other than signs of erythropoietic regeneration).
- A robust morphological threshold for suspecting TMA (MAHA of MAHAT) diagnosis in adult and full-term neonates is set at the percentage of schistocytes above 1%. Nevertheless, a lack of schistocytes does not exclude a priori the diagnosis of TMA.
- The widespread availability of automated, routine available FRC counts represents a potentially powerful tool for screening. The absence of FRC by automated analysis can be used to exclude with high likelihood the presence of schistocytes on the blood film. The exception is represented by samples with high MCV, which should be checked using an OM in the appropriate diagnostic setting. Samples with a positive automated FRC count should be validated with an OM to confirm the presence of schistocytes and to enumerate them (modified).
- Evidence-based reference values of the schistocyte percentage using the OM on PB smears are 1% or less in normal adults and full-term neonates, and 5% or less in premature babies.
- A PB smear for schistocyte count should be prepared within three hours from blood collection from samples kept at room temperature, or within eight hours from samples refrigerated at around 4°C, to avoid storage-induced morphological RBC lesions.
TMA is a life-threatening condition with a natural history that can only be modified by early and accurate diagnosis and treatment. The detection of more than 1% schistocytes on PB smears in adults and full-term neonates remains a robust cytomorphological threshold that favors a diagnosis of TMA. Routine automated FRC counts (as part of a full blood count), which are available in most laboratories, are a potentially powerful screening tool and are capable when confirmed with the OM of potentially intercepting patient samples with suspected TMA for which a specific clinical request for schistocyte search has not yet been formulated.
References
Zini, et al, The International Council for Standardization in Haematology (ICSH) recommendations for the identification, diagnostic value, and quantitation of schistocytes, International J Lab Hematol 2012
Zini G, et al, 2021 update of the 2012 ICSH Recommendations for identification, diagnostic value, and quantitation of schistocytes: Impact and revisions, Int J Lab Hematol, 2021;43(6):1264-1271.

How to resolve AdBlock issue?
How to resolve AdBlock issue?